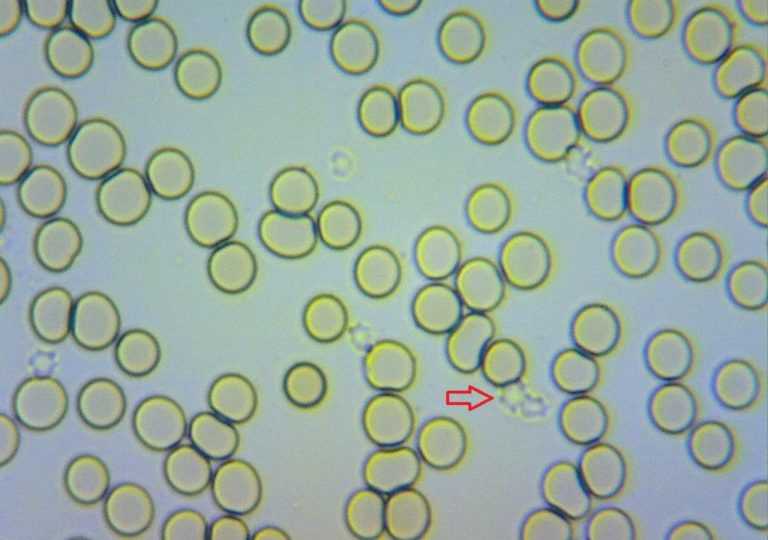

Η νέα τεχνική ελέγχου ούρων χρησιμοποιεί μικροσκοπία ατομικής δύναμης (AFM) για να αναπτύξει χάρτη της επιφάνειας των κυττάρων. Ερευνητές, με επικεφαλής μηχανικούς του Tufts University, ανέπτυξαν τρόπο να σαρώνουν τα ούρα για να εντοπίσουν στοιχεία υπογραφής καρκινικών κυττάρων. Πρόκειται για μη παρεμβατική μέθοδο ελέγχου για καρκίνο στην ουροδόχο κύστη, που θα μπορούσε να κάνει πιο εύκολη την εξέταση σε σχέση με τις τρέχουσες εξετάσεις που απαιτούν οπτικό έλεγχο της κύστης.
Η νέα τεχνική ελέγχου ούρων χρησιμοποιεί μικροσκοπία ατομικής δύναμης (AFM) για να αναπτύξει χάρτη της επιφάνειας των κυττάρων, μέθοδο που οι ερευνητές λένε πως είναι πιο ακριβής από την οπτική εξέταση. Είναι επίσης πιο βολική-εξετάζει ανθρώπους που έχουν κίνδυνο, καθώς και επιζώντες από καρκίνο στην κύστη οι οποίοι έχουν μόνο να δώσουν δείγμα ούρων.
Έως τώρα, το τεστ έχει περισσότερο από 90% ευαισθησία στον εντοπισμό του καρκίνου στην ουροδόχο κύστη σε σύγκριση με ποσοστό 20-80% των υπαρχόντων τεστ. Οι ερευνητές ελπίζουν να εφαρμόσουν το τεστ τους σε άλλα είδη όγκων, περιλαμβανομένων του πεπτικού συστήματος, του παχέος εντέρου και του τραχήλου της μήτρας.
Ο καρκίνος της ουροδόχου κύστης μπορεί να εκδηλωθεί με αιματουρία, πόνο κατά τη διάρκεια της ούρησης, συχνοουρία και αίσθημα ανάγκης για διούρηση χωρίς όμως να εξέρχονται ούρα. Εμφανίζεται πιo συχνά στους άνδρες παρά στις γυναίκες και ενώ στους άνδρες είναι ο τέταρτος πιο συχνός καρκίνος, στις γυναίκες είναι ο όγδοος.
Το κάπνισμα, μέσω της εισπνοής πολλών τοξικών ουσιών που περιέχει ο καπνός, μπορεί να προκαλέσει καρκίνο της ουροδόχου κύστης. Πολλές τοξικές ουσίες που εισέρχονται στον οργανισμό μέσω του καπνίσματος αποβάλλονται περνώντας από την ουροδόχο κύστη. Σχεδόν όλοι οι ασθενείς που πάσχουν από τον καρκίνο αυτό είναι καπνιστές.
Η έγκαιρη διάγνωση του καρκίνου αυτού είναι πολύ σημαντική διότι όταν η θεραπεία γίνει νωρίς αποφεύγεται η εξάπλωση του βαθύτερα στην ουροδόχο κύστη αλλά και σε άλλα γειτονικά όργανα και ιστούς.